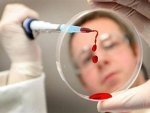
� ������ ������������ ������ ������ ������ �� ������� ������

Новости
14:28 03 февраля 2016
В Курске зафиксирован первый случай смерти от свиного гриппа
Первой жертвой свиного гриппа в Курске стал 31-летний безработный местный житель. По данным регионального Роспотребнадзора, мужчина скончался 1 февраля в больнице, а заболел 25 января. Он не был привит от гриппа, не проводил никакую профилактику. В стационар пациента доставили только на пятый день после начала заболевания.
В инфекционной больнице больной находился под наблюдением врачей в реанимационном отделении. Однако мужчину не спасла искусственная вентиляция легких и другие реанимационные мероприятия.
В целом эпидемиологи оценивают ситуацию с распространением гриппа в Курской области как тяжелую. Пороговые уровни заболеваемости превышены по всем возрастным группам. Сохраняется тенденция к росту числа заболевших. Уже зарегистрировано 86 пациентов с вирусом А (H1N1). Среди них почти два десятка беременных женщин, их всех госпитализировали для постоянного присмотра. Всего вирус гриппа лабораторно подтвердили у 118 курян.
Общее число заболевших гриппом и ОРВИ в период с 25 по 31 января составило 11,6 тысячи человек. Эпидпорог превышен на 84%.
Кстати, препарат «Тамифлю», который медики рекомендуют принимать в период эпидемии, выпускается в Курске. Это совместный проект ОАО «Фармстандарт-Лексредства» и швейцарской компании «Рош». Как заверили журналистов на предприятии, препарат производится в штатном режиме. Но лекарства нет ни в курских аптеках, ни в других регионах страны. Специалисты из Санкт-Петербурга считают, что на «Тамифлю» образовался ажиотажный спрос (при этом цена лекарства на курс лечения – около 1 тысячи рублей), поэтому его просто не успевают производить и распространять в дилерскую сеть.
Прочтений: 4166
Зарегистрируйтесь или войдите, чтобы оставить комментарий (сейчас комментариев: 0)
Ссылки по теме:
Нашли опечатку? Выделите её и нажмите ссылку
 Трансляция новостей на Вашем
компьютере установить
Трансляция новостей на Вашем
компьютере установить
 Сделать стартовой
Сделать стартовой Добавить в избранное
Добавить в избранное
